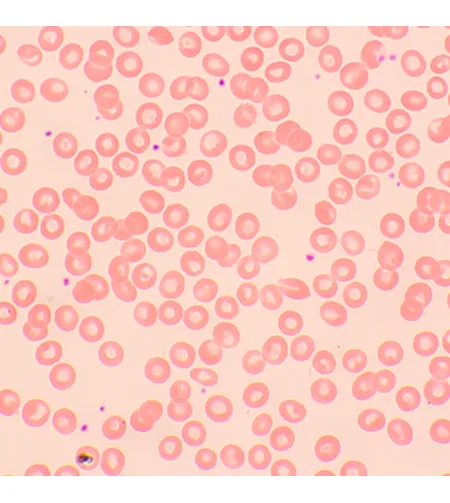
MAGUS Bio 250TL Biological Microscope

MAGUS Bio 250TL Biological Microscope

- Availability: In another stock
- Brand: MAGUS
- Product Code: L_82891
- Weight: 10.50kg
- Dimensions: 43.10cm x 27.10cm x 63.00cm
- EAN: 5905555018058
This offer ends in:
Available Options
Monthly payment: 488.24€
Period: 3 months

The MAGUS Bio 250TL microscope studies thin sections and smears of biological samples. Observations are made using the brightfield microscopy technique in transmitted light. A 3-watt LED serves as the light source, and the optics feature infinity plan achromatic objectives. The microscope supports additional accessories, including darkfield, polarization, and phase contrast devices. This microscope is the ideal choice for laboratory analysis, research, and teaching.
Optics
The trinocular head includes two eyepiece tubes for observations and a vertical tube for mounting digital camera (not included). The tubes are 30° inclined for comfortable long working hours and can be rotated 360° to fit the height of the observer. There is a diopter adjustment ring that is located on the left tube.
Objectives are mounted in a 5-slot revolving nosepiece – four objectives are included, one slot for an additional objective is left free. Any optional objective can be installed in the free slot, allowing for additional magnification within the magnification range. The user can see the objective inserted into the optical path during the observation as the revolving nosepiece is oriented toward the interior. It keeps the space above the stage free.
The magnification range is from 40x to 1000x (only applies to the basic configuration). If you add additional objectives, the upper magnification limit will be increased.
Illumination
LEDs mounted at the bottom of the microscope provide bright and even illumination of the object. The color temperature remains the same when changing brightness. The power of the illumination is 3W. It has an operating life of 50,000 hours. The lighting system is powered by an AC power supply.
By adjusting the position of the Abbe condenser and opening or closing the aperture and field diaphragms, it is possible to set up the Köhler illumination. You can use sliders for darkfield and phase contrast techniques (a special slot is provided in the condenser). With the slider, switching between the research techniques is very fast.
Stage and focusing mechanism
The stage has no positioning rack. Therefore, it will not disturb you during observations, and the microscope itself will take up less space on the desktop. The mechanical attachment that moves the sample is removable (useful for manual scanning).
Coarse and fine focusing are used for focus adjustment. The knobs are located on both sides. As they are located closer to the base, you do not have to hold your hands in the air while working. You can relax them on the table. The coarse focusing has a lock knob and tension adjustment. The focus adjustment is smooth and effortless.
Accessories
The capabilities of the MAGUS Bio 250TL microscope can be enhanced with the line of accessories, including eyepieces, objectives, calibration slides, digital cameras, darkfield, polarization, and phase contrast devices.
Key features:
- Trinocular head, revolving nosepiece for 5 objectives, infinity plan achromatic optics
- The eyepiece tubes rotate 360° for easy adjustment to fit the height of the observer
- There is a diopter adjustment ring on the left tube, coarse and fine focusing
- The coarse focusing has a lock knob and tension adjustment
- The Abbe condenser is centered and height-adjustable, and the field and aperture diaphragms allow for the Köhler illumination setup
- Transmitted light source – 3W LED with adjustable brightness, powered by 220V power supply
- Option to install additional accessories
The kit includes:
- Base with a power input, transmitted light source, focusing mechanism, stage, condenser, and revolving nosepiece
- Trinocular head
- Infinity plan achromatic objective: 4x/0.1
- Infinity plan achromatic objective: 10x/0.25
- Infinity plan achromatic objective: 40x/0.65 (spring-loaded)
- Infinity plan achromatic objective: 100x/1.25 (spring-loaded)
- Eyepieces 10x/22mm with a long eye relief (2 pcs.)
- Eyecups (2 pcs.)
- Filters (4 pcs.)
- C-mount camera adapter
- Bottle of the immersion oil
- Hex key wrench
- AC power cord
- Dust cover
- User manual and warranty card
Available on request:
- 10x/22mm eyepiece with scale
- 12.5x/14mm eyepiece (2 pcs.)
- 15x/15mm eyepiece (2 pcs.)
- 20x/12mm eyepiece (2 pcs.)
- 25x/9mm eyepiece (2 pcs.)
- Infinity plan achromatic objective: 20x/0.4
- Infinity plan achromatic objective: 60x/0.80 (spring-loaded)
- Phase contrast device
- Phase slider
- Darkfield condenser NA 0.9
- Oil darkfield condenser NA 1.36–1.25
- Darkfield slider
- Polarization device
- Digital camera
- Calibration slide
| Brand | MAGUS |
| Warranty, years | 5 |
| EAN | 5905555018058 |
| Package size (LxWxH), cm | 43.1x27.1x63 |
| Shipping Weight, kg | 10.5 |
| Type | biological, light/optical |
| Head | trinocular |
| Head inclination angle | 30 ° |
| Magnification, x | 40–1000 basic configuration (*optional: 40–1200/1250/1500/1600/2000/2500) |
| Magnification range | from 800x to 1280x |
| Eyepiece tube diameter, mm | 30 |
| Eyepieces | 10х/22mm, eye relief: 10mm (*optional: 10x/22mm with scale, 12.5x/14; 15x/15; 20x/12; 25x/9) |
| Objectives | infinity plan achromatic: 4x/0.1; 10x/0.25; 40xs/0.65; 100xs/1.25 (oil); parfocal distance: 45mm (*optional: 20x/0.4; 60хs/0.80) |
| Revolving nosepiece | for 5 objectives |
| Working distance, mm | 21 (4x); 5 (10x); 0.66 (40xs); 0.36 (100xs); 8.8 (20x); 0.465 (60xs) |
| Interpupillary distance, mm | 48 — 75 |
| Stage, mm | 180x150 |
| Stage moving range, mm | 75/50 |
| Stage features | two-axis mechanical stage, without a positioning rack |
| Eyepiece diopter adjustment, diopters | ±5 (on the left tube) |
| Condenser | Abbe condenser, N.A. 1.25, center-adjustable, height-adjustable, adjustable aperture diaphragm, a slot for a darkfield slider and phase contrast slider, dovetail mount |
| Diaphragm | adjustable aperture diaphragm, adjustable iris field diaphragm |
| Focus | coaxial, coarse focusing (21mm, 39.8mm/circle, with a lock knob and tension adjusting knob) and fine focusing (0.002mm) |
| Illumination | LED |
| Brightness adjustment | yes |
| Power supply | 220±22V, 50Hz, AC network |
| Light source type | 3W LED |
| Light filters | yes |
| Operating temperature range,°C | 5 — 35 |
| Ability to connect additional equipment | phase contrast device (condenser and objectives), darkfield condenser (dry or oil), polarization devices (polarizer and analyzer) |
| User level | experienced users, professionals |
| Assembly and installation difficulty level | complicated |
| Application | laboratory/medical |
| Illumination location | lower |
| Research method | bright field |
| Pouch/case/bag in set | dust cover |
| Weight, kg | 8 |
| Dimensions, mm | 200x436x400 |
| Nozzle | Gemel head (Siedentopf, 360° rotation) |
| Microscopes | |
| Body material | Aluminum |
| Condenser | Abbe condenser NA 1.25 |
| Diaphragm | adjustable iris field diaphragm |
| Experiment kit included | No |
| Eyepiece tube diameter, mm | 30 |
| Eyepieces | WF 10x |
| Head | Trinocular |
| Illumination | LED |
| Illumination location | Lower Illumination |
| Magnification range | 40–1000x |
| Objectives | 4x, 10x, 40xs, 100xs |
| Pouch/case/bag in set | No |
| Research method | Bright Field |
| Shipping Weight, kg | 0.121 |
| Stage type | two-axis mechanical |
| Type of Build | Biological |
| User level | experienced users, professionals |
| Warranty, years | 5 |














